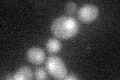
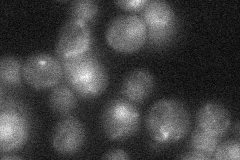
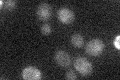

View description
Kinetochore checkpoint WD40 repeat protein that localizes to kinetochores during prophase and metaphase, delays anaphase in the presence of unattached kinetochores; forms complexes with Mad1p-Bub1p and with Cdc20p, binds Mad2p and Mad3p
Localization:
Intensity:
Fold change:
Significance:
-
C’ GFP library in SD
nucleus19.79 -
N' NOP1pr-GFP in SD

cytosol60.5846 -
N' TEF2pr-mCherry in SD

cytosol61.8756 -
N' NATIVEpr-GFP in SD
punctate18.8806 -
N' TEF2pr-VC and Cyto-VN in SD

cytosol34.9474 -
C’ GFP library in SD+DTT

nucleus16.580.83No -
C’ GFP library in SD+H2O2

nucleus19.690.99No -
C’ GFP library in Starvation Media
nucleus19.460.98No -
C’ GFP library on the background of Pup2-DaMP

nucleus -
C’ GFP library on the background of CCT mutant

nucleus17.73180.895649No
